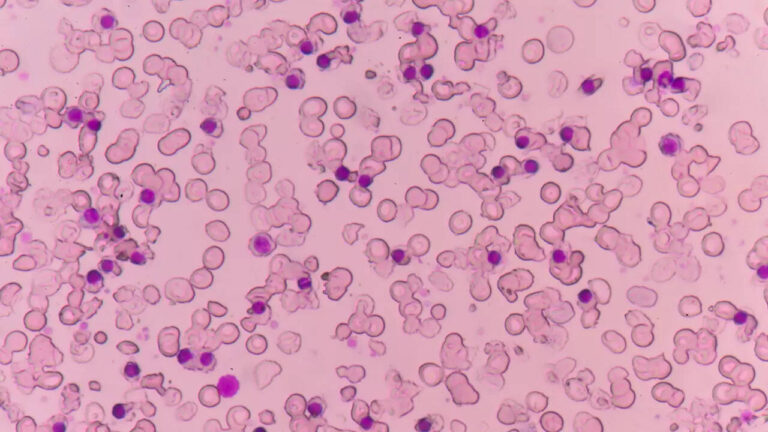
What is Alpha Thalassemia? How is it diagnosed?

A recent Australian study reveals that exercise can significantly slow breast cancer cell growth. Researchers at Edith...
Life & Style
Elon Musk briefly ceded his position as the world’s richest person to Oracle co-founder Larry Ellison, a...
Alpha thalassemia is diagnosed through a combination of clinical evaluation, blood tests, and genetic analysis. Early detection...
Houseplants have once again become a major part of home décor, adding freshness, beauty, and a sense...
With all the noise, deadlines, and distractions in life, it’s becoming harder and harder to soothe the...
The birth control pills, IUDs and hormonal implants were purchased by U.S.A.I.D. for women in low-income countries....
Fitness coach Dan Go believes the secret to looking and feeling younger lies in what you eat...
Leg lengthening surgery, once a critical treatment for children with leg-length discrepancies or patients recovering from severe...
Starting your day with the same breakfast might seem like a convenient routine, but is it truly...
The US government just made its biggest-ever bust of illegal e-cigarettes. Officials from the FDA and US...